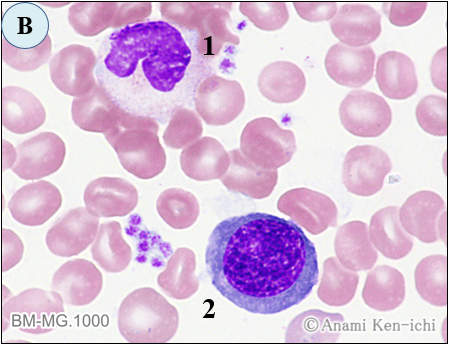

大相撲秋場所(2022.9.11~25)は、東前頭3枚目玉鷲関が千秋楽に高安関との同門対決を制して3年ぶり2度目の賜杯(優勝)を手にしました。玉鷲関は1横綱、3大関すべてを破り、13勝2敗の成績で優勝しました。これは37年ぶりの快挙で37歳10か月での幕内優勝は、年6場所制が定着した1958年以降では最年長であり、“角界の鉄人”にふさわしい優勝となりました。また、玉鷲関の鉄人ぶりは出場記録にも表れており、2004年初場所からの連続出場記録は秋場所中に元関脇貴闘力関の1456回を抜き歴代単独3位となり、千秋楽には1463回まで記録を伸ばしました。
玉鷲関は、モンゴル・ウランバート出身で片男波(かたおなみ)部屋に所属、身長189cm、体重172kg、 “突き押し相撲”を得意とし、趣味は意外にも小物やお菓子作りだそうで雑誌などにも本人が作ったクッキーや壁掛けなどを紹介されているそうです。
秋場所で快挙を成し遂げた玉鷲関ですが、コロナ渦の中で取り組んだ厳しい稽古が実を結んだそうです。所属する片男波部屋は、力士数は4名で十両以上の関取は玉鷲一人だけの小さな所帯のため、日頃の稽古で力を出し切る稽古相手がいません。また、コロナ感染拡大で出稽古が自粛されたために関取衆との稽古もままならないが状況が続いたそうです。このきびしい環境の中、部屋の若い衆を同時に何人も相手にすることで稽古不足を補い、鍛錬を積み重ね幕の内最高の栄誉を手にしました。玉鷲関の年齢を感じさせない“突き押し相撲”は、まだまだ続きそうですので大相撲から目が離せません。
さて、6月13日は何の記念日かご存知でしょうか。1987年6月13日、プロ野球広島東洋カープの衣笠祥雄(きぬがさ さちお)選手が通算2131試合の連続出場し、当時の世界新記録を達成したことを記念して“鉄人の日”が制定されたそうです。プロスポーツでは怪我や困難に強く、長年に渡って試合に出場する選手は敬意を込めて“鉄人”と呼ばれ、ハンマー投げの室伏広治選手やJリーグの三浦知良選手などみなさんもご存知かと思います。また、“鉄人”とはスポーツ選手だけでなく、強い意思を持ちながら何か続けている人を示していると考えますので、みなさんの身近にも“鉄人”がいらっしゃるかもしれません。この「マンスリー形態マガジン」も今月号で138回を迎えることができました。まだまだ、“鉄人”の域には達していませんが、暫くはお付き合いをいただければと思います。
形態マガジン号キャプテン 阿南 建一

今回の細胞編は、骨髄において鑑別を要する細胞を出題しました。細胞の基本的な読み方に基づき判定してみてください。
症例編は、白血球数の著増と芽球の増加のわりに細胞化学的所見の情報が少ないようです。形態診断を支持する検査と鑑別疾患を考えてみてください。
問題1
BM-MG.1000

BM-MG.1000

BM-MG.1000

BM-MG.1000

問題2
【成人】 発熱(38.5℃)が持続するため来院、白血病の疑いのもと骨髄検査が施行された。
WBC 90,000/μL、RBC 220万/μL、Hb 6.6g/dL、Ht 20.5%、MCV 93.1fL、PLT 5.0万/μL、
BM-NCC 15.7万/μL
PB-MG.1000

BM-MG.1000

BM-PO.1000

BM-PAS.1000/EST.400

問題 1
骨髄の紛らわしい細胞の鑑別に挑みます。
【正答】
A-1.細網細胞
B-1.桿状核球 2.多染性赤芽球
C-1.幼若好塩基球
D-1.多染性赤芽球 2.リンパ球 3.多染性赤芽球 4.前骨髄球
【解説】

A-1.細胞径21μm大、核は類円形でクロマチンは繊細網状、細胞質辺縁は不鮮明で顆粒を有します。大型で細胞膜の不鮮明と核質の繊細さから非造血細胞群の細網細胞と思われます。
B-1.細胞径13μm大、核は棒状で陥没がみられ、クロマチンは粗剛で細胞質が橙紅色の色調から桿状核球と思われます。
B-2.細胞径15μm大、核は円形でクロマチンは凝集し、細胞質は青紫色の色調から多染性赤芽球と思われます。通常の多染性赤芽球の大きさ(9~12μm)に比べると大きいことから大赤芽球が考えられます。

C-1.細胞径20μm大、核は偏在しクロマチンは粗剛傾向、細胞質は軽度好塩基性で辺縁部に顕著な空胞を認め、その一部は核の上にも存在します。この空胞は染色の過程で顆粒が抜け出たものと思われ、大型のことから幼若好塩基球(前骨髄球あたり)が考えられます。核の上の空胞は顆粒が抜けた跡と思われます。

D-1.細胞径10μm大、核はほぼ円形で偏在しクロマチンは凝集傾向、細胞質は僅かながら多染性の色調から多染性赤芽球と思われます。
D-2.細胞径11μm大、核は円形でクロマチンは粗剛、細胞質は好塩基性が強度のことから小リンパ球と思われます。
D-3.細胞径11μm大、核は円形で偏在しクロマチンは凝集傾向、細胞質は青紫色の色調から多染性赤芽球と思われます。
D-4.細胞径16μm大、周囲の赤血球に押されて委縮気味です。核は偏在しクロマチンは顆粒状気味、細胞質の粗大な顆粒は一次顆粒と思われ前骨髄球が考えられます。
問題 2
この症例の形態所見から考えられる疾患は何でしょうか。また、鑑別する疾患とそのポイントも考えてください。
【成人】 発熱(38.5℃)が持続するため来院、白血病の疑いのため骨髄検査が施行された。
WBC 90,000/μL、RBC 220万/μL、Hb 6.6g/dL、Ht 20.5%、MCV 93.1fL、PLT 5.0万/μL、BM-NCC 15.7万/μL
成人例で、風邪症状(発熱38.5℃)が続くため来院、汎血球減少と白血球数増加がみられました。
【解説】




A.[PB-MG.1000] 白血球数増加(90,000/μL)の百分率は芽球が99%と増加していました。芽球は好中球(13μm大)の大きさでN/C比は高く核小体を認めました。
B.[BM-MG.1000] 骨髄は正形成で芽球は99%と増加し、末梢血と同様に小型でN/C比が高く明瞭な核小体を認めました。
C.[骨髄-PO.1000] 芽球はPO染色に陰性でした。
D.[骨髄-PAS/EST.1000/400] 芽球の一部にPAS染色の点状陽性がみられ、EST二重染色は陰性でした。
【臨床診断】
末梢血および骨髄の芽球は90%を超えていたことから急性白血病を疑いました。芽球はPO染色に陰性であったこと、またPAS染色に一部が点状の陽性を示していたことから急性リンパ芽球性白血病(ALL)を考え、PO陰性の急性骨髄性白血病(AML-M0)は除外診断としました。診断に有用となる免疫表現型ではCD7のみが高率発現でした。従って、AML-M0は否定され、CD7はTリンパ球の発現抗原からpre T-ALLと診断されましたが、幹細胞レベルのCD34,HLA-DR単独発現と同様に幹細胞性白血病、分類不能型白血病も考慮すべきとされました。
本型のような症例は、WHO分類(2017)ではPO染色陰性、EST染色陰性、骨髄系・リンパ球系いずれのマーカーも示さない急性未分化白血病として記載され、帰属不明の未分化な病型から予後不良とされています。本例も造血幹細胞が腫瘍化したAMLと思われ、治療後約3週間で急性転化の経過をたどりました。またHLA-DR抗原の単独発現も経験しましたがやはり予後不良でした。私的に幹細胞は小型のイメージが強く、本症は形態的にも幹細胞レベルの急性白血病が推測されそうです。
これから先のページでは、医療関係者の方々を対象に医療機器・体外診断薬等の製品に関する情報を提供しております。当社製品を適正に使用していただくことを目的としており、一部の情報では専門的な用語を使用しております。
一般の方への情報提供を目的としたものではありませんので、ご了承ください。
医療関係者の方は、次のページへお進みください。
(お手数ですが、「進む」ボタンのクリックをお願いします)